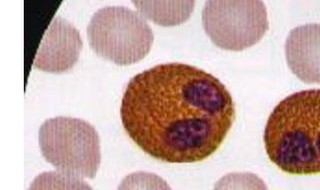
嗜酸性细胞偏高的危害 嗜酸性粒细胞偏高要怎么办

1、嗜酸粒细胞偏高的情况下,大多数都是由于有过敏,各种皮肤病,或者是有寄生虫感染引起,没有这些情况的时候,做检查只是有偏高的情况下,一般对身体影响也不是很大。
2、举措建议:如果有过敏的症状的情况下是可以适当的用抗过敏的药物来治疗,没有症状也需要检查一下有没有寄生虫感染,检查都正常的情况下,一般不需要用药物来治疗。
3、注意事项:平时要注意避免吃有刺激性的,容易引起过敏的食物,也需要带孩子定期去医院做检查。
健康养生2022-04-11 09:57:36佚名
1、嗜酸粒细胞偏高的情况下,大多数都是由于有过敏,各种皮肤病,或者是有寄生虫感染引起,没有这些情况的时候,做检查只是有偏高的情况下,一般对身体影响也不是很大。
2、举措建议:如果有过敏的症状的情况下是可以适当的用抗过敏的药物来治疗,没有症状也需要检查一下有没有寄生虫感染,检查都正常的情况下,一般不需要用药物来治疗。
3、注意事项:平时要注意避免吃有刺激性的,容易引起过敏的食物,也需要带孩子定期去医院做检查。
白头发有变黑的人吗 少年白很困扰青少年